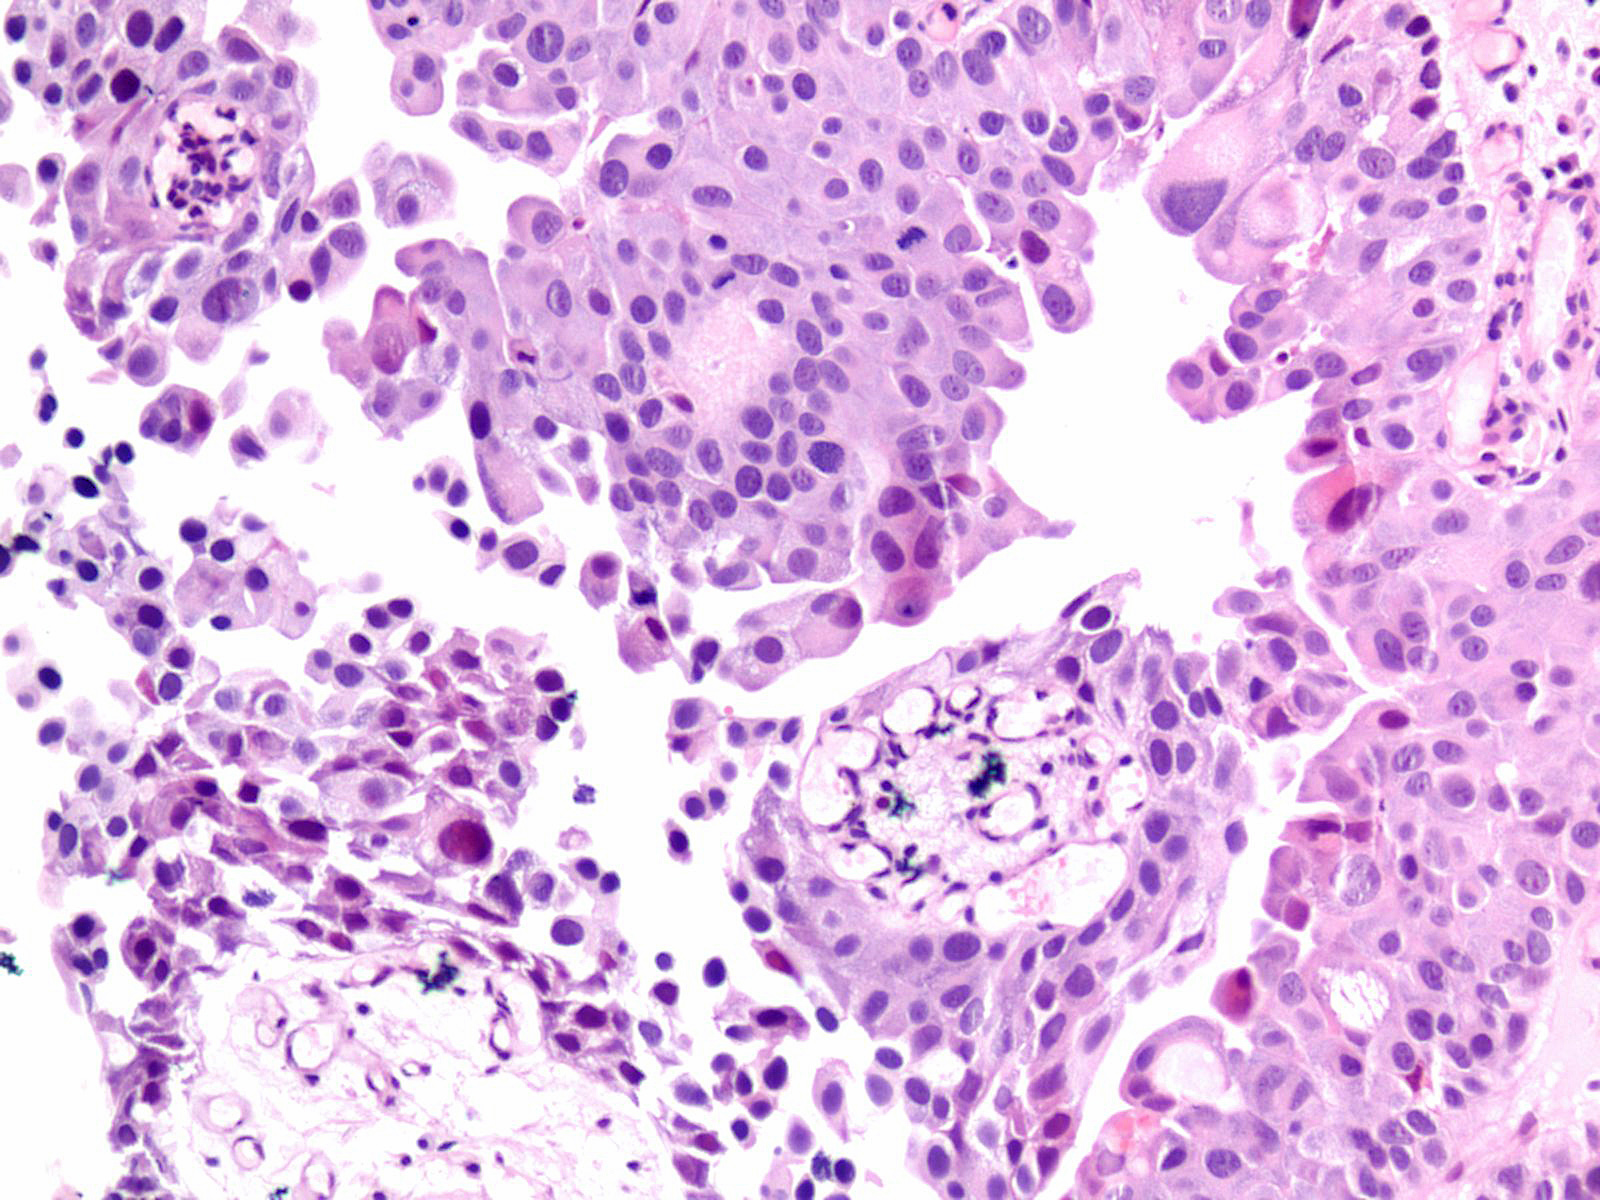
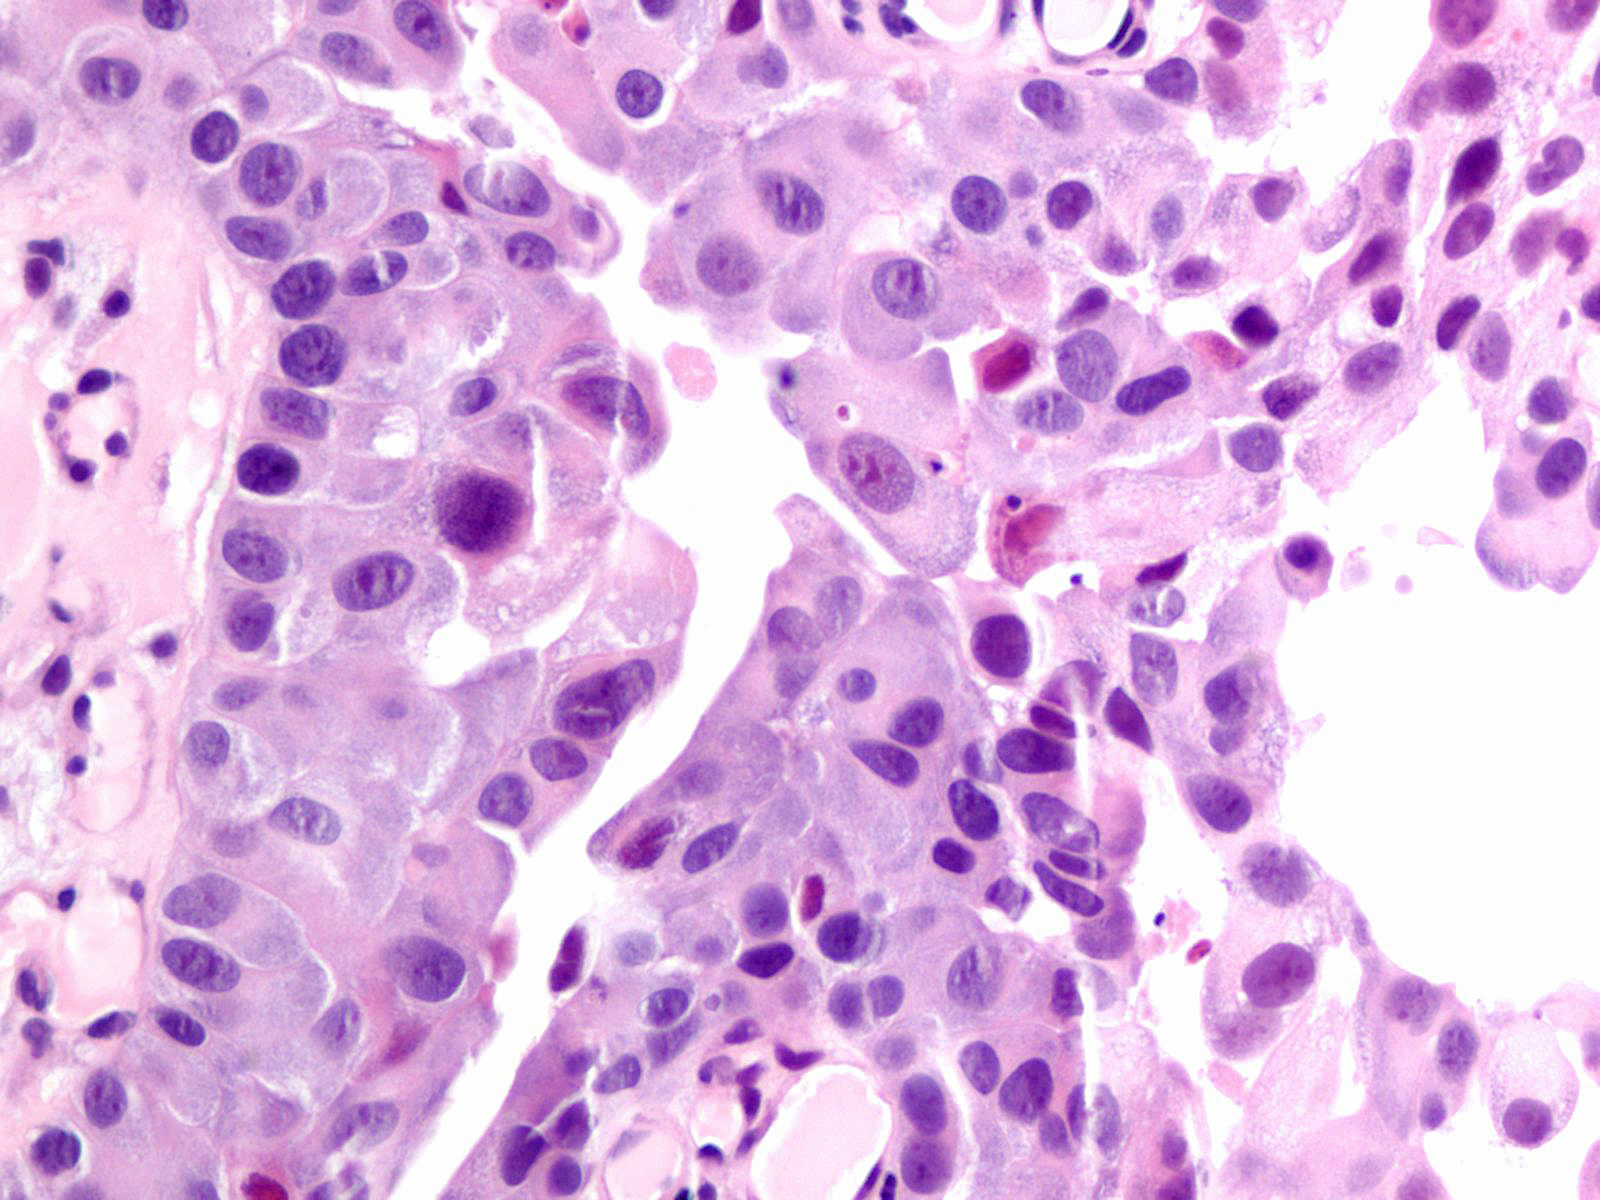

Case ID: 267
Publication date: 06 Oct, 2015
Consensus grade: High-grade papillary urothelial carcinoma (HG-PUC)
Show diagnosis by expert panel members| User | Diagnosis | Difficulty | Comment |
|---|---|---|---|
| Pathologist 1 | High-grade papillary urothelial carcinoma (HG-PUC) | Typical | |
| Pathologist 2 | High-grade papillary urothelial carcinoma (HG-PUC) | Typical | |
| Pathologist 3 | High-grade papillary urothelial carcinoma (HG-PUC) | Typical | |
| Pathologist 4 | High-grade papillary urothelial carcinoma (HG-PUC) | Typical | |
| Pathologist 5 | High-grade papillary urothelial carcinoma (HG-PUC) | Typical | |
| Pathologist 6 | High-grade papillary urothelial carcinoma (HG-PUC) | Typical | |
| Pathologist 7 | High-grade papillary urothelial carcinoma (HG-PUC) | Typical | |
| Pathologist 8 | High-grade papillary urothelial carcinoma (HG-PUC) | Typical | |
| Pathologist 9 | High-grade papillary urothelial carcinoma (HG-PUC) | Typical | |
| Pathologist 10 | High-grade papillary urothelial carcinoma (HG-PUC) | Typical |
No specific comment. |
| Pathologist 11 | High-grade papillary urothelial carcinoma (HG-PUC) | Typical | |
| Pathologist 12 | High-grade papillary urothelial carcinoma (HG-PUC) | Typical | |
| Pathologist 13 | High-grade papillary urothelial carcinoma (HG-PUC) | Typical | |
| Pathologist 14 | High-grade papillary urothelial carcinoma (HG-PUC) | Typical | |
| Pathologist 15 | High-grade papillary urothelial carcinoma (HG-PUC) | Typical | |
| Pathologist 16 | High-grade papillary urothelial carcinoma (HG-PUC) | Typical | |
| Pathologist 17 | High-grade papillary urothelial carcinoma (HG-PUC) | Typical | |
| Pathologist 18 | High-grade papillary urothelial carcinoma (HG-PUC) | Typical | |
| Pathologist 19 | High-grade papillary urothelial carcinoma (HG-PUC) | Bordering on lower | |
| Pathologist 20 | High-grade papillary urothelial carcinoma (HG-PUC) | Typical | |
| Pathologist 21 | High-grade papillary urothelial carcinoma (HG-PUC) | Typical |
Case description (by case creator):
Lesion shows marked variation in nuclear size, shape and chromatin. Architecturally, cells appear loosely cohesive and the epithelium is disorganized. Mitotic figures are seen.